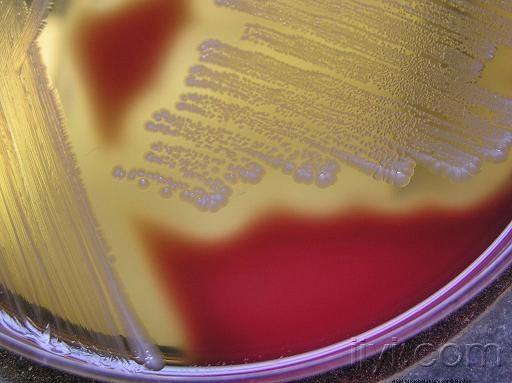
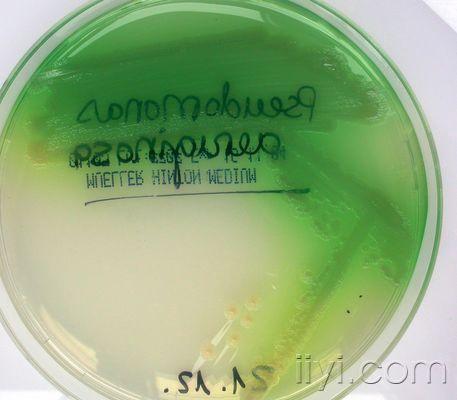
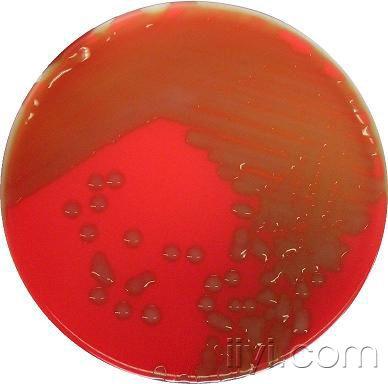
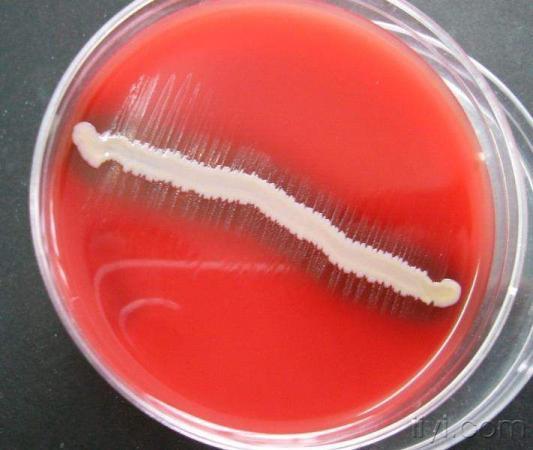
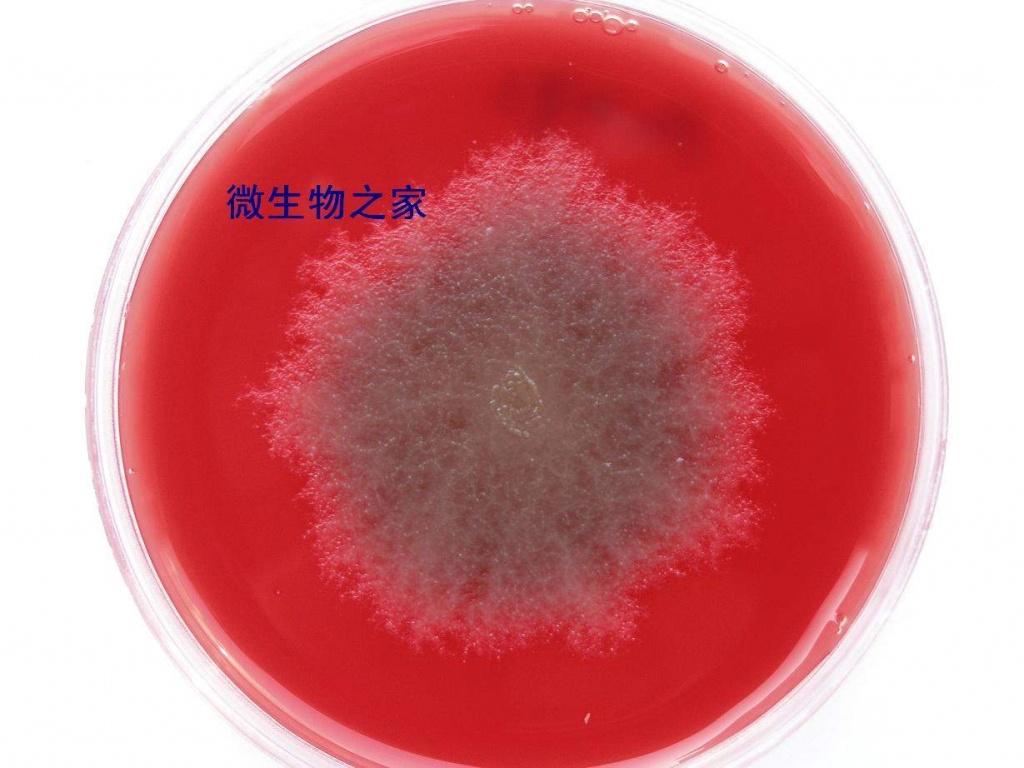
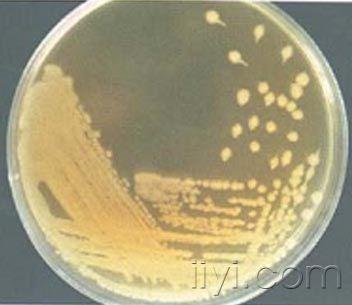

各种细菌菌落
+关注
本帖最后由 走过风雪 于 2010-7-14 16:23 编辑
β溶血性链球菌

表皮葡萄球菌

波斯坦芽孢杆菌

产色素铜绿假单胞菌

肺炎链球菌α溶血

副流感嗜血杆菌之卫星现象

金黄色葡萄球菌

枯草芽孢杆菌

溶血菌落图片

梭形芽孢杆菌

炭疽杆菌

衣氏放线菌

2010-07-14 16:19:37 19411 浏览
β溶血性链球菌
表皮葡萄球菌

波斯坦芽孢杆菌

产色素铜绿假单胞菌
肺炎链球菌α溶血
副流感嗜血杆菌之卫星现象
金黄色葡萄球菌

枯草芽孢杆菌

溶血菌落图片

梭形芽孢杆菌
炭疽杆菌
衣氏放线菌










